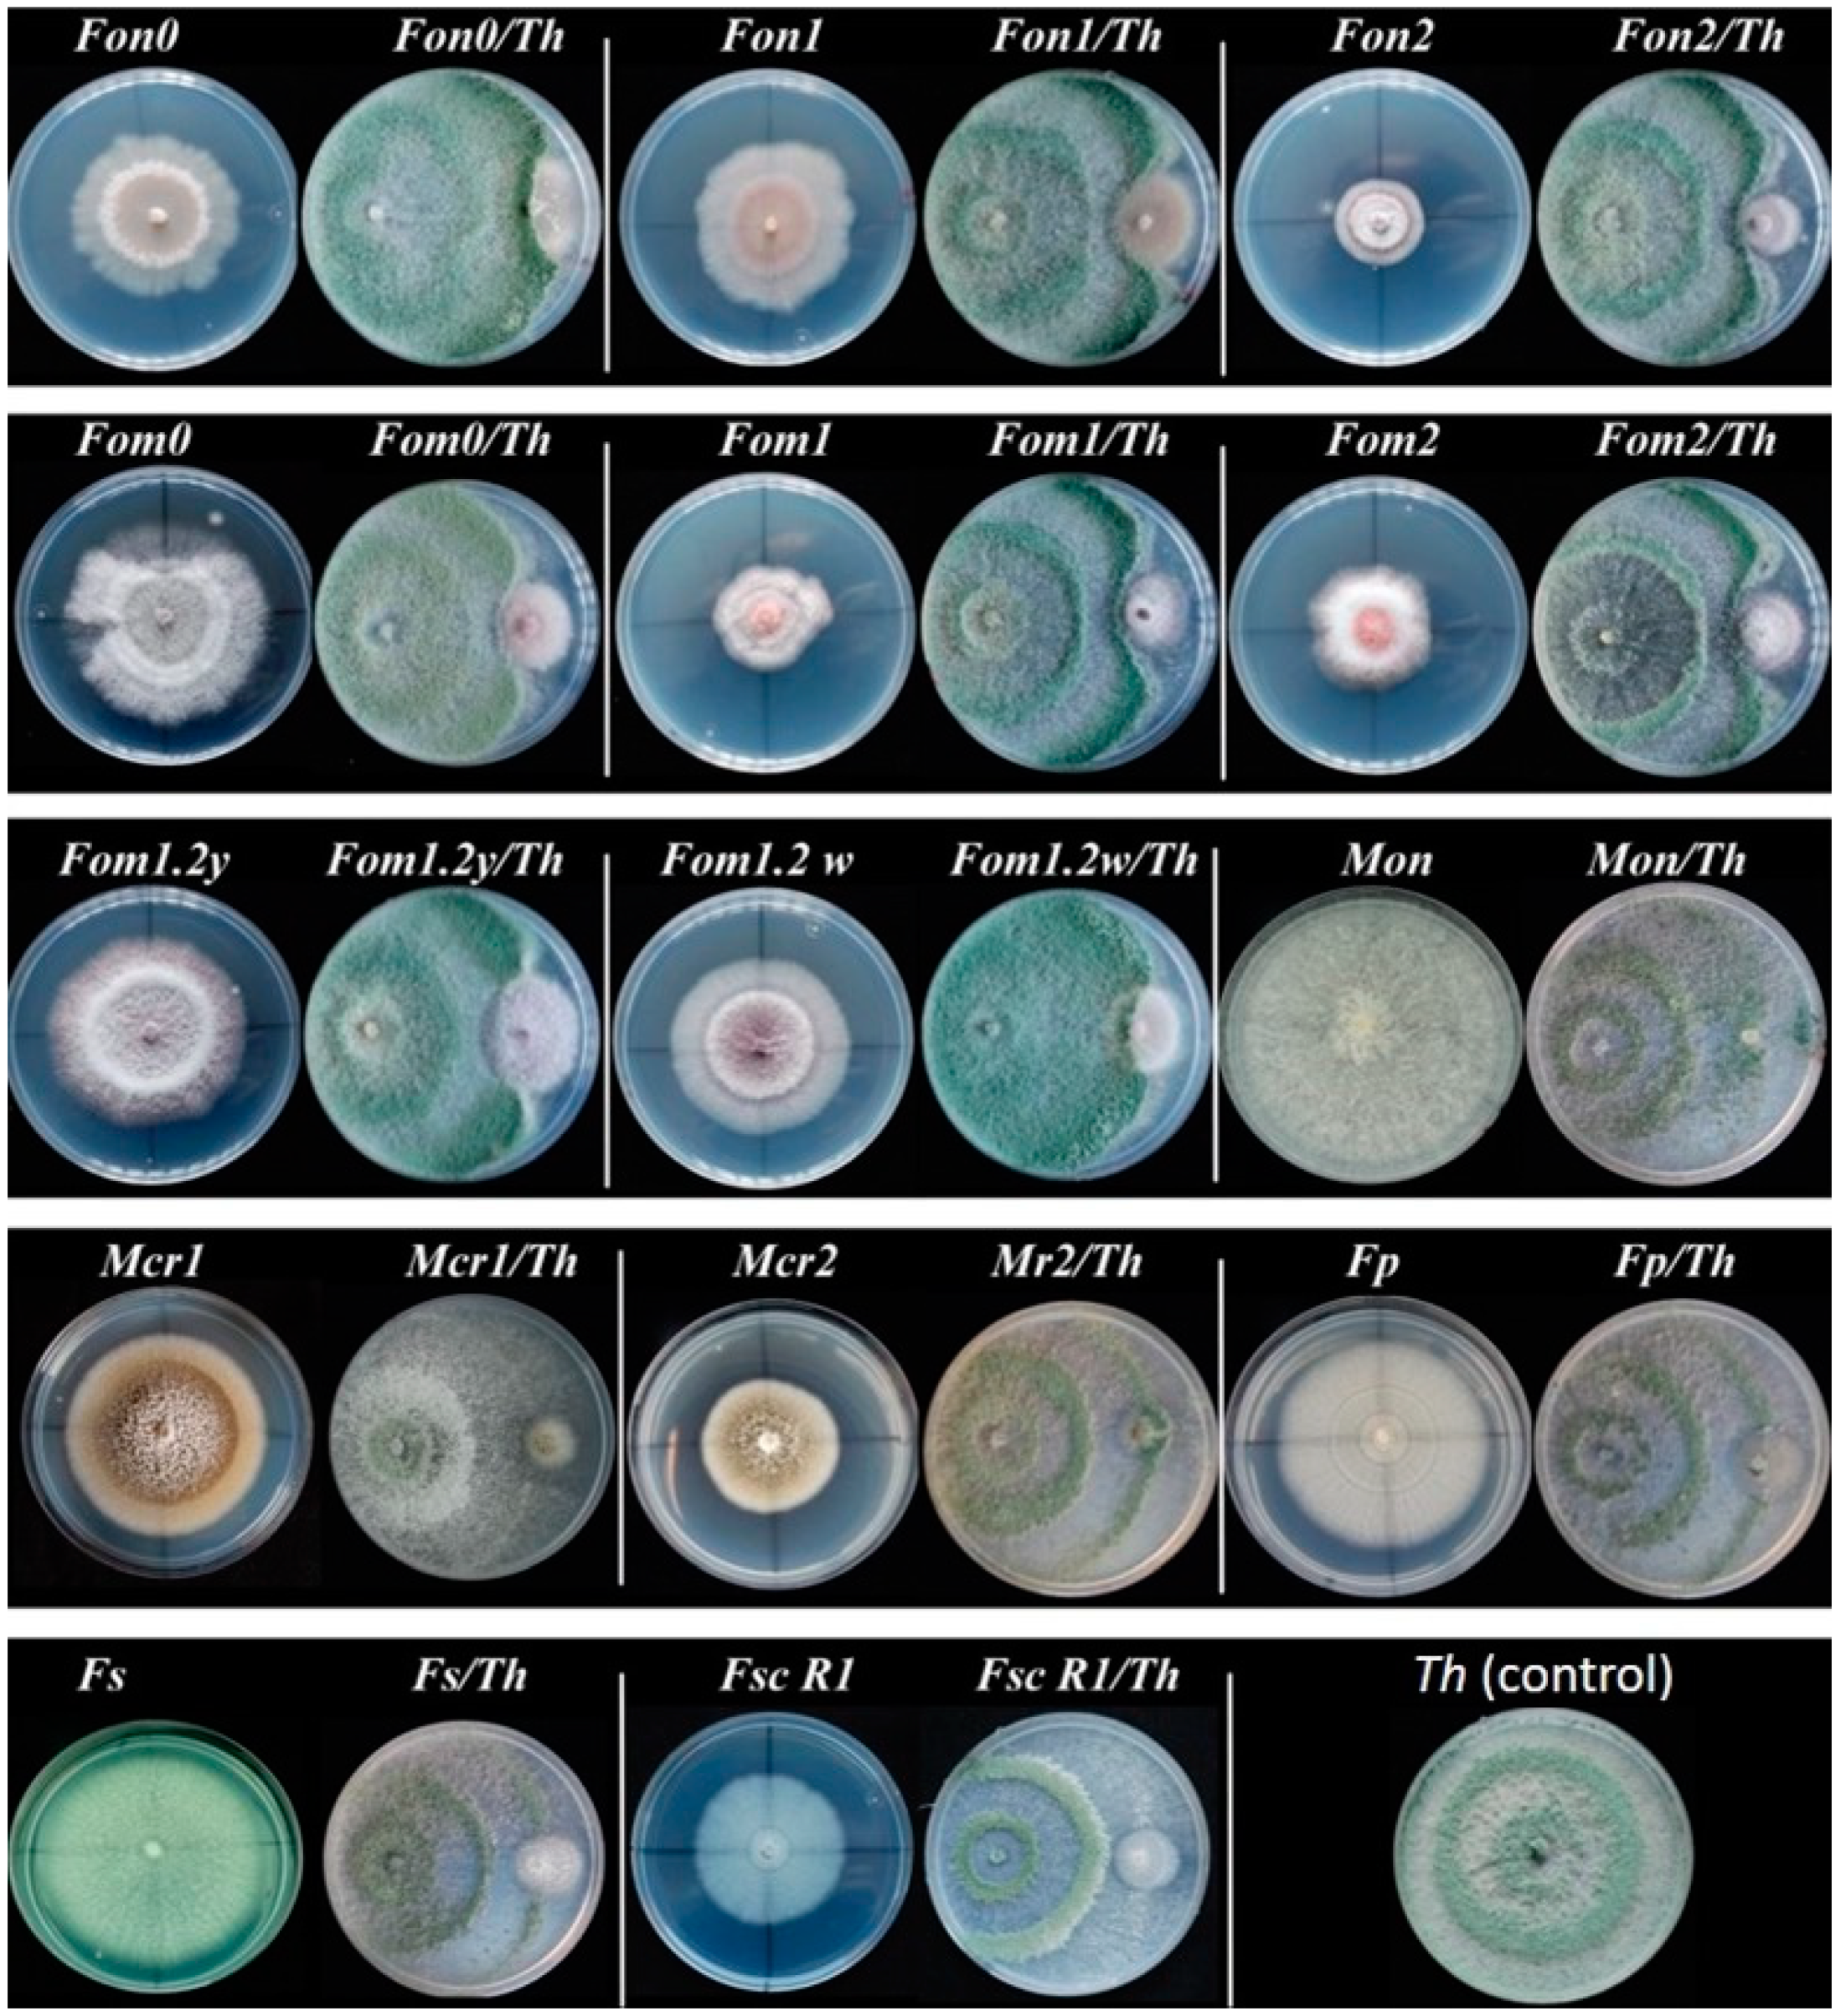
Agronomy 10 00820 g002
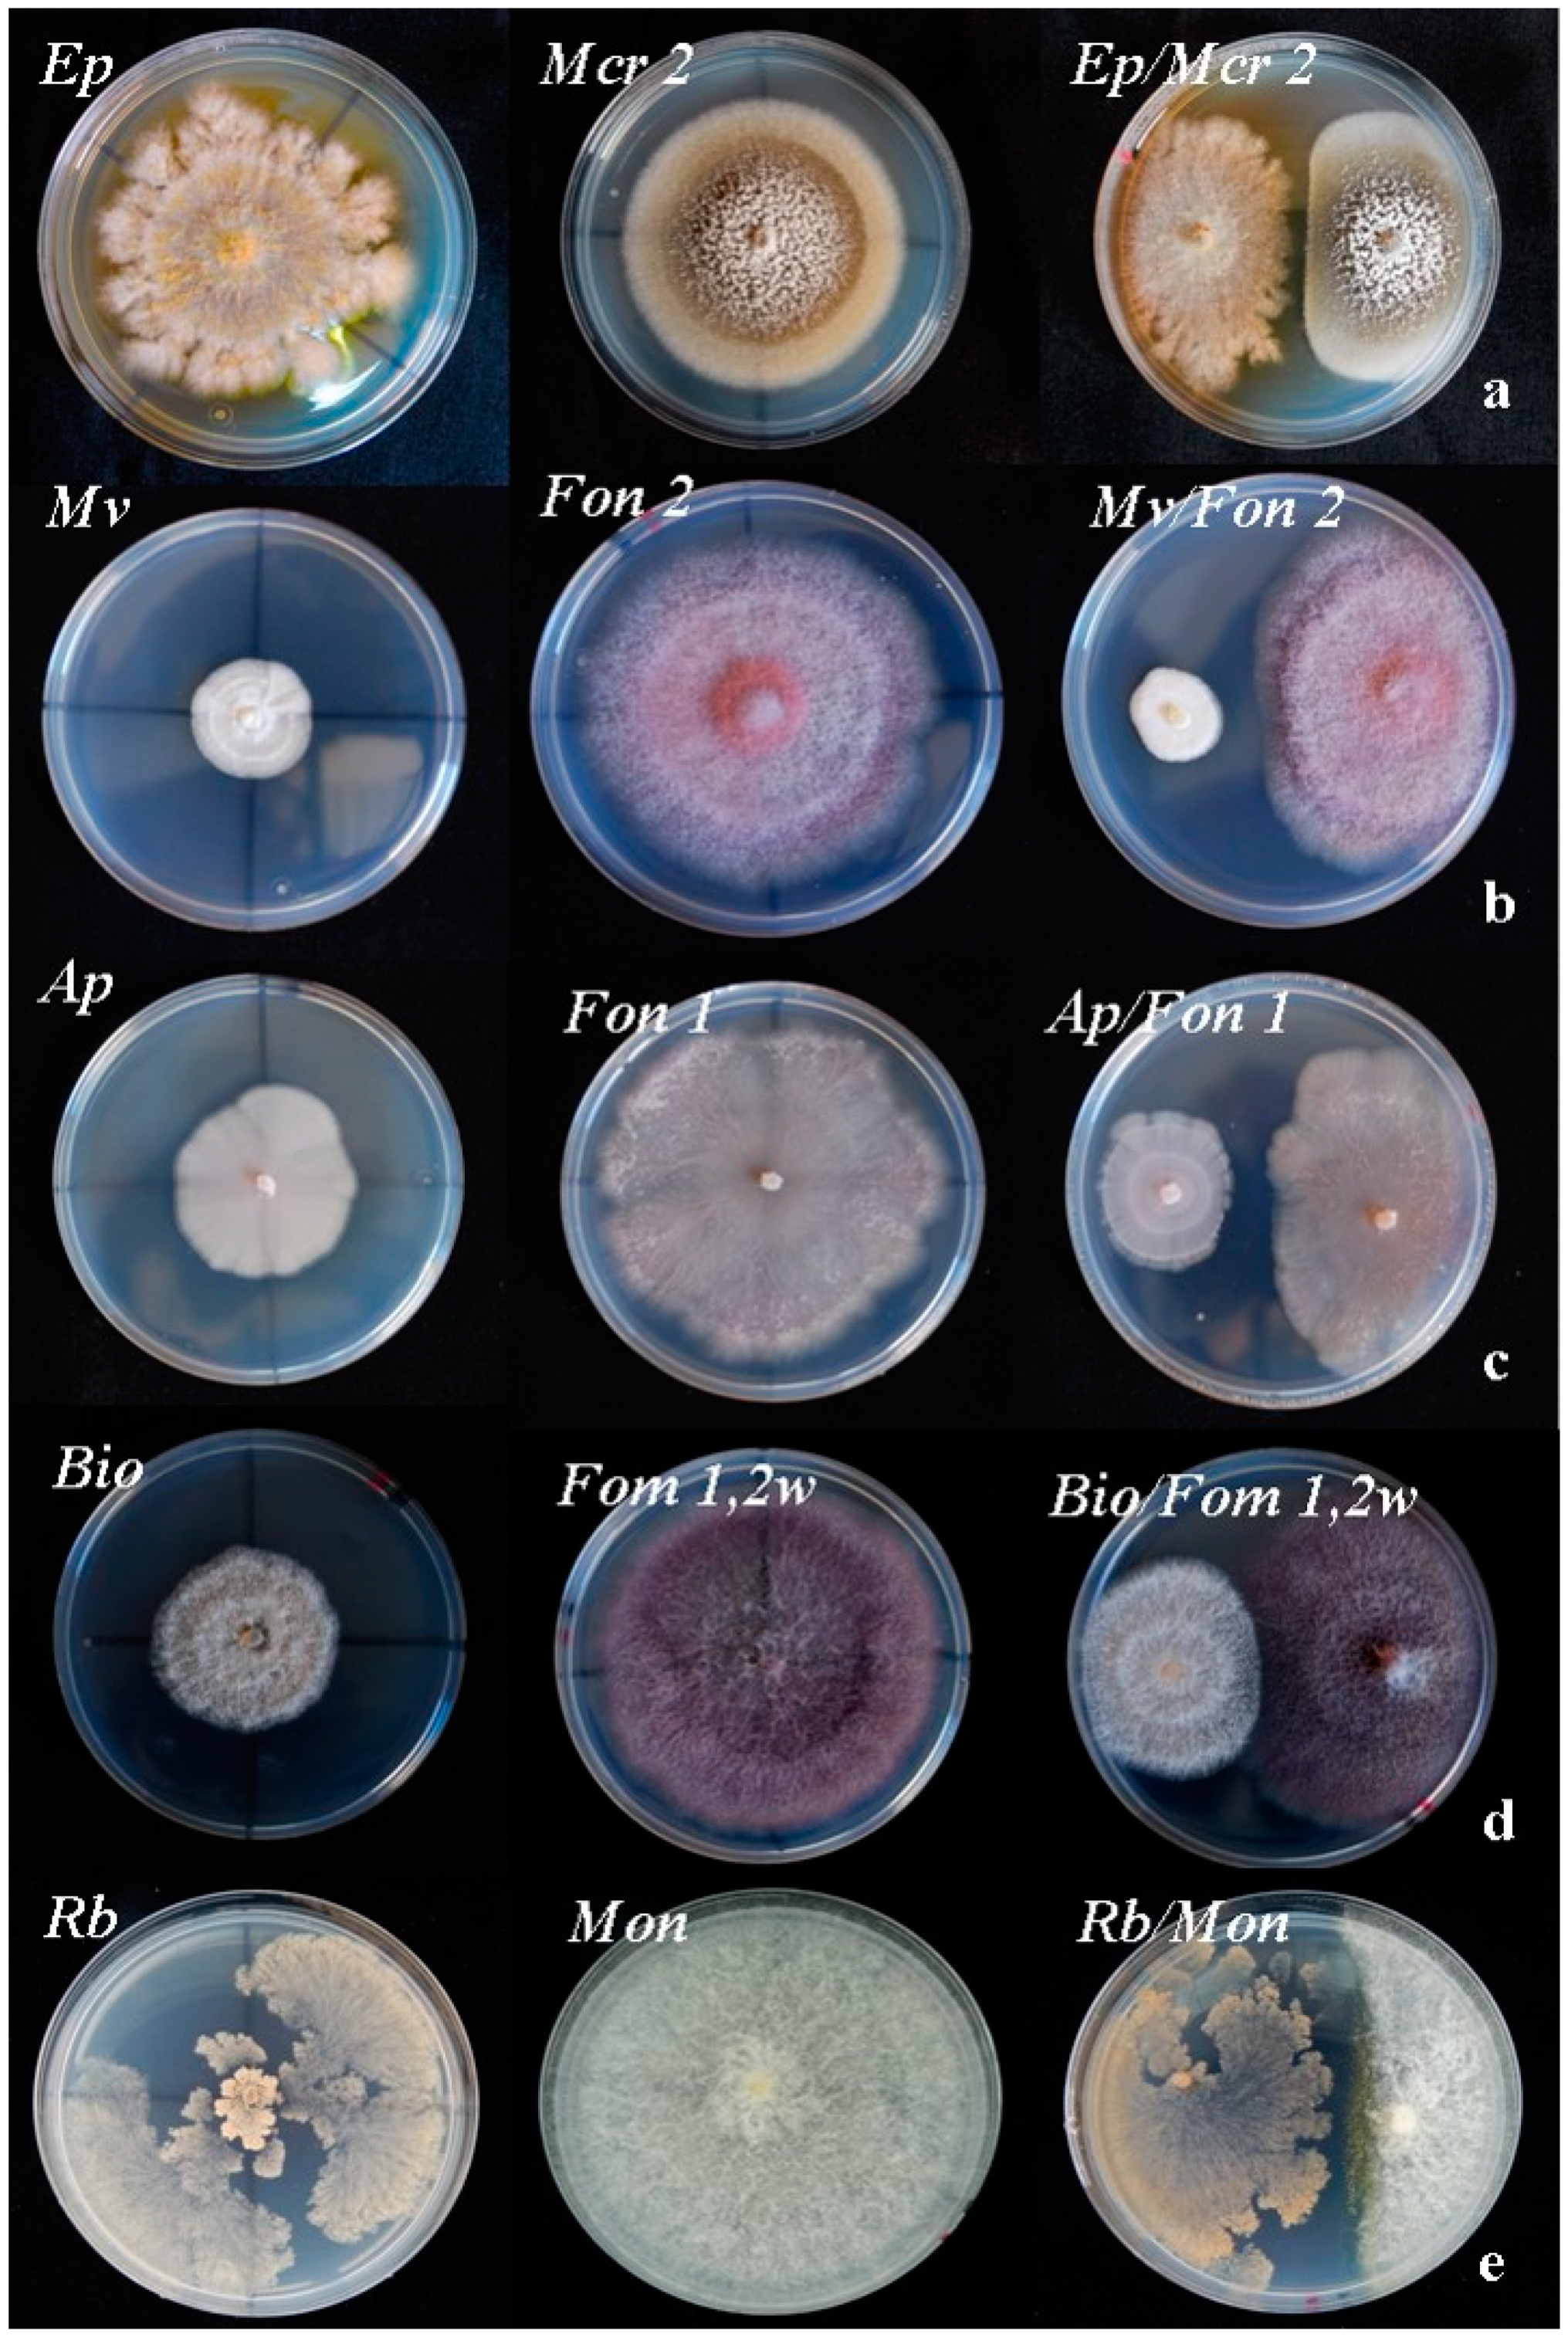
Agronomy 10 00820 g003

Fungal Endophytes as Biocontrol Agents against the Main Soil-Borne Diseases of Melon and Watermelon in Spain
Abstract
1. Introduction
2. Materials and Methods
2.1. Fungal Isolates
2.2. Morphological and Molecular Characterization of Fungal Isolates
2.3. Selection of Microbial Antagonists
2.4. Dual Plate Cultures
2.5. Evaluation of Fungicide Effects of Secondary Metabolites from Epicoccum Purpurascens
2.6. In Vivo Biocontrol Assay
3. Results
3.1. Endophytic Fungi Associated with Watermelon Plants. Selection of Microbial Antagonists
3.2. Dual Culture Pathogens-Biocontrol Agents (BCA)
3.3. Fungicide Effects of Secondary Metabolites from Epicoccum Purpurascens
3.4. Bioassay Tests of Biocontrol with Trichoderma Spp in Watermelon and Melon Seedlings
4. Discussion
4.1. Fungal Isolates
4.2. In Vitro Antagonism
4.3. Fungicide Effects of Secondary Metabolites from Epicoccum Purpurascens
4.4. Plant Protection Assays
5. Conclusions
Supplementary Materials
Author Contributions
Funding
Conflicts of Interest
References
- FAO. Food and Agricultural Organization of the United Nations: FAOSTAT. 2018. Available online: http://www.fao.org/faostat/en/#data/QC (accessed on 1 January 2020).
- Pitrat, M. Melon. In Handbook of Plant Breeding, vol Vegetables I: Asteraceae, Brassicaceae, Chenopodiaceae, and Cucurbitaceae; Prohens, J., Nuez, F., Eds.; Springer: Berlin/Heidelberg, Germany, 2008; pp. 283–315. [Google Scholar]
- Wehner, T.C. Watermelon. In Handbook of Plant Breeding, vol Vegetables I: Asteraceae, Brassicaceae, Chenopodiaceae, and Cucurbitaceae; Prohens, J., Nuez, F., Eds.; Springer: Berlin/Heidelberg, Germany, 2008; pp. 381–418. [Google Scholar]
- Martyn, R.D. Fusarium Wilt of Watermelon: 120 Years of Research. Hortic. Rev. 2014, 42, 349–442. [Google Scholar] [CrossRef]
- Boughalleb, N.; Ben Salem, I.; Beltrán, R.; Vicent, A.; Pérez–Sierra, A.; Abad–Campos, P.; García–Jiménez, J.; Armengol, J. Occurrence of Monosporascus cannonballus in watermelon fields in Tunisia and factors associated with ascospore density in soil. J. Phytopathol. 2010, 158, 137–142. [Google Scholar] [CrossRef]
- Gómez, J.; Serrano, Y.; Pérez, A.; Porcel, E.; Gómez, R.; Aguilar, M.I. Fusarium solani f. sp. cucurbitae, affecting melon in Almería province, Spain. Australas. Plant Dis. Notes 2014, 9, 136. [Google Scholar]
- Armengol, J.; José, C.M.; Moya, M.J.; Sales, R.; Vicent, A.; García–Jiménez, J. Fusarium solani f. sp. cucurbitae race 1, a potential pathogen of grafted watermelon production in Spain. Bull. OEPP 2000, 30, 179–183. [Google Scholar] [CrossRef]
- González, V.; Armengol, J.; Garcés–Claver, A. First report of Fusarium petroliphilum causing fruit rot of butternut squash in Spain. Plant Dis. 2018, 102, 1662. [Google Scholar] [CrossRef]
- Ben Salem, I.; Correia, K.C.; Boughalleb, N.; Michereff, S.J.; León, M.; Abad–Campos, P.; García–Jiménez, J.; Armengol, J. Monosporascus eutypoides as another cause of Monosporascus root rot and vine decline in Tunisia, and evidence that M. cannonballus and M. eutypoides are distinct species. Plant Dis. 2013, 97, 737–743. [Google Scholar] [CrossRef]
- Zitter, T.; Hopkins, D.; Claude, T. Plagas y Enfermedades de las Cucurbitáceas; Mundi–Prensa: Madrid, España, 2004; p. 88. [Google Scholar]
- Petkar, K.; Harris–Shultz, H.; Wang, M.T.; Brewer, L.; Sumabat, P.J. Genetic and phenotypic diversity of Fusarium oxysporum f. sp. niveum populations from watermelon in the southeastern United States. PLoS ONE 2019, 14, e0219821. [Google Scholar] [CrossRef]
- Gómez, J.; Guerra–Sanz, J.M.; Sánchez–Guerrero, M.C.; Serrano, Y.; Melero–Vara, J.M. Crown rot of zucchini squash caused by Fusarium solani f. sp. cucurbitae in Almería Province, Spain. Plant Dis. 2008, 92, 1137. [Google Scholar]
- González, V.; García–Martínez, S.; Ruiz–Martínez, J.J.; Flores–León, A.; Picó, B.; Garcés–Claver, A. First report of Neocosmospora falciformis causing witl and root rot of Muskmelon in Spain. Plant Dis. 2019. [Google Scholar] [CrossRef]
- Shafique, H.A.; Sultana, V.; Ehteshamul–Haque, S.; Athar, M. Management of soil–borne diseases of organic vegetables. J. Plant Prot. Res. 2016, 56, 221–230. [Google Scholar] [CrossRef]
- Giménez, C.; Cabrera, R.; Reina, M.; González–Coloma, A. Fungal Endophytes and their Role in Plant Protection. Curr. Org. Chem. 2007, 11, 707–720. [Google Scholar] [CrossRef]
- Gafni, A.; Calderon, C.E.; Harris, R.; Buxdorf, K.; Dafa–Berger, A.; Zeilinger–Reichert, E.; Levy, M. Biological control of the cucurbit powdery mildew pathogen Podosphaera xanthii by means of the epiphytic fungus Pseudozyma aphidis and parasitism as a mode of action. Front. Plant Sci. 2015, 6, 132. [Google Scholar] [CrossRef]
- Mei, L.; Guang–Shu, M.A.; Lian, H.; Su, X.; Tian, Y.; Huang, W.; Mei, J.; Jiang, X. The effects of Trichoderma on preventing cucumber fusarium wilt and regulating cucumber physiology. J. Integr. Agric. 2019, 18, 607–617. [Google Scholar] [CrossRef]
- Romero, D.; Vicente, A.; Zeriouh, H.; Cazorla, F.; Fernández–Ortuño, D.; Tores, J.; Pérez–García, A. Evaluation of biological control agents for managing cucurbit powdery mildew on greenhouse–grown melon. Plant Pathol. 2007, 56, 976–986. [Google Scholar] [CrossRef]
- Collinge, D.B.; Jørgensen, H.J.L.; Meike, A.C.L.; Manzotti, A.; Ntana, F.; Rojas, E.C.; Jensen, B. Searching for novel fungal biological control agents for plant disease control among endophytes. In Endophytes for a growing World; Hodkinson, T.R., Doohan, F.M., Saunders, M.J., Murphy, B.R., Eds.; Cambrigde Univerisity Press: Cambrigde, UK, 2019; pp. 23–164. [Google Scholar]
- Singh, P.P.; Shin, Y.C.; Park, C.S.; Chung, Y.R. Biological control of fusarium wilt of cucumber by chitinolytic bacteria. Phytopathology 1999, 89, 92–99. [Google Scholar] [CrossRef] [PubMed]
- El Hartiti, A.; Hichar, A.; Bazdi, O.; El Habchi, S.; Ounine, K. Biocontrol of Fusarium wilt of cucumber (Cucumis sativus L.) by Bacillus sp. World J. Pharm. Life Sci. 2016, 2, 314–322. [Google Scholar]
- Lin–Qi, H.; Niu, Y.-C.; Su, L.; Deng, H.; Lyu, H. The potential of endophytic fungi isolated from cucurbit plants for biocontrol of soilborne fungal diseases of cucumber. Microbiol. Res. 2019, 231, 126369. [Google Scholar] [CrossRef]
- Dennis, C.; Webster, J. Antagonistic properties of species–groups of Trichoderma: III. Hyphal interaction. Trans. Br. Mycol. Soc. 1971, 57, 363–369. [Google Scholar] [CrossRef]
- Ezziyyani, M.; Pérez, S.; Requena, M.; Rubio, L.; Candela, L. Biocontrol de Streptomyces rochei –Ziyani–, de la podredumbre del pimiento (Capsicum annuum L.) causada por Phytophthora capsici. An. Biol. 2004, 26, 69–78. [Google Scholar]
- Worasatit, N.; Sivasithamparam, K.; Ghisalberti, E.L.; Rowland, C. Variation in pyrone production, lytic enzymes and control of rhizoctonia root rot of wheat among single–spore isolates of Trichoderma koningii. Mycol. Res. 1994, 98, 1357–1363. [Google Scholar] [CrossRef]
- Ortiz, A.; Orduz, S. In vitro evaluation of Trichoderma and Gliocladium antagonism against the symbiotic fungus of the leaf–cutting ant Atta cephalotes. Mycopathology 2001, 150, 53–60. [Google Scholar] [CrossRef] [PubMed]
- Martyn, R.D.; Bruton, B.D. An initial survey of the United States for races of Fusarium oxysporum f. sp. niveum. HortScience 1989, 24, 696–698. [Google Scholar]
- Zabalgogeazcoa, I. Review. Fungal endophytes and their interaction with plant pathogens. Span. J. Agric. Res. 2008, 6. [Google Scholar] [CrossRef]
- Pacifico, D.; Squartini, A.; Crucitti, D.; Barizza, E.; Schiavo, F.; Muresu, R.; Carimi, F.; Zottini, M. The Role of the Endophytic Microbiome in the Grapevine Response to Environmental Triggers. Front. Plant Sci. 2019, 10, 1256. [Google Scholar] [CrossRef] [PubMed]
- Sánchez–Fernández, R.E.; Sánchez–Ortiz, B.L.; Sandoval–Espinosa, Y.K.; Ulloa–Benítez, A.; Armendáriz–Guillén, B.A.; García–Méndez, M.C.; Macías–Rubalcava, M.L. Hongos endófitos: Fuente potencial de metabolitos secundarios bioactivos con utilidad en agricultura y medicina. Revista Especializada En Ciencias Químico–Biológicas 2013, 16, 132–146. [Google Scholar] [CrossRef]
- Cota, L.V.; Maffia, L.A.; Mizubuti, E.S.G.; Macedo, P.E.F.; Antunes, R.F. Biological control of strawberry gray mold by Clonostachys rosea under field conditions. Biol. Control. 2008, 46, 515–522. [Google Scholar] [CrossRef]
- Di Francesco, A.; Ugolini, L.; D’Aquino, S.; Pagnotta, E.; Mari, M. Biocontrol of Monilinia laxa by Aureobasidium pullulans strains: Insights on competition for nutrients and space. Ind. J. Food Microbiol. 2017, 248, 32–38. [Google Scholar] [CrossRef]
- Clarke, T.C.; Shetty, K.G.; Jayachandran, K.; Norland, M.R. Myrothecium verrucaria– a potential biological control agent for the invasive ‘old world climbing fern’ (Lygodium microphyllum). BioControl 2007, 52, 349–411. [Google Scholar] [CrossRef][Green Version]
- Gupta, J. Efficacy of Biocontrol Agents against Phytophthora infestans on Potato. Int. J. Eng. Sci. Comput. 2016, 6, 2249–2252. [Google Scholar]
- Talontsi, F.M.; Dittrich, B.; Schüffler, A.; Sun, H.; Laatsch, H. Epicoccolides: Antimicrobial and antifungal polyketides from an endophytic fungus Epicoccum sp. associated with Theobroma cacao. Eur. J. Or Chem. 2013, 15, 3174–3180. [Google Scholar] [CrossRef]
- González, V.; Onco, M.P.; Susan, V.R. Biology and systematics of the form genus Rhizoctonia. Span. J. Agric. Res. 2006, 4, 55–79. [Google Scholar] [CrossRef]
- Gupta, V.K.; Schmoll, M.; Herrera–Estrella, A.; Upadhyay, R.S.; Druzhinina, I.; Tuohy, M.G. (Eds.) Biotechnology and Biology of Trichoderma; Elsevier: Amsterdam, The Netherlands, 2014; pp. 1–650. [Google Scholar] [CrossRef]
- Bastakoti, S.; Belbase, S.; Manandhar, S.; Arjyal, C. Trichoderma species as biocontrol agents against soil–borne fungal pathogens. Nepal J. Biotechnol. 2017, 5, 39–45. [Google Scholar] [CrossRef]
- Brunner, K.; Zeilinger, S.; Ciliento, R.; Woo, S.; Lorito, M.; Kubicek, C.; Mach, R. Improvement of the Fungal Biocontrol Agent Trichoderma atroviride To Enhance both Antagonism and Induction of Plant Systemic Disease Resistance. Appl. Environ. Microbiol. 2005, 71, 3959–3965. [Google Scholar] [CrossRef]
- Boughalleb, N.; Ben Salem, I.; M’Hamdi, M. Evaluation of the efficiency of Trichoderma, Penicillium, and Aspergillus species as biological control agents against four soil–borne fungi of melon and watermelon. Egypt. J. Biol. Pest Col. 2018, 28. [Google Scholar] [CrossRef]
- Kareem, K.; Ugoji, O.; Aboaba, O. Biocontrol of Fusarium wilt of cucumber with Trichoderma longibrachiatum NGJ167 (Rifai). Br. Microbiol. Res. J. 2016, 16, 1–11. [Google Scholar] [CrossRef]
- Benítez, T.; Rincón, A.M.; Limón, M.C.; Codón, A.M. Biocontrol mecanisms of Trichoderma strains. Int. Microbiol. 2004, 7, 249–260. [Google Scholar]
- Fernández, R.J.; Suárez, C.L. Antagonismo invitro de Trichoderma harzianum Rifai sobre Fusarium oxysporum. Rev. Fac. Nac. Agron. Medellín 2009, 62, 4743–4748. [Google Scholar]
- Srivastava, M. Biological Control of Soil Borne Pathogens (Fusarium oxysporum f.sp. cucumerinum.) of Cucumber (Cucumis sativus) by Trichoderma sp. Int. J. Adv. Res. 2016, 5, 1–9. [Google Scholar] [CrossRef]
- Zhang, J.X.; Bruton, B.D.; Howell, C.R.; Miller, M.E. Potential of Trichoderma virens for biocontrol of root rot and vine decline in Cucumis melo L. caused by Monosporascus cannonballus. Subtrop. Plant Sci. 1999, 51, 29–37. [Google Scholar]
- Rhouma, A.; Ben Salem, I.; M’Hamdi, M.; Boughalleb, N. Antagonistic potential of certain soilborne fungal bioagents against Monosporascus root rot and vine decline of watermelon and promotion of its growth. Nov. Res. Microbiol. J. 2018, 2, 85–100. [Google Scholar] [CrossRef]
- Aly, A.; Abdel–Sattar, M.; Omar, M.; Abd–Elsalam, K. Differential antagonism of Trichoderma sp. against Macrophomina phaseolina. J. Plant Prot. Res. 2007, 47, 91–102. [Google Scholar]
- Lee, H.; Kim, J.-C.; Hong, K.-S.; Kim, C.-J. Evaluation of a Fungal Strain, Myrothecium roridum F0252, as a Bioherbicide Agent. Plant Pathol. J. 2008, 24, 453–460. [Google Scholar] [CrossRef]
- Elkhateeb, W.; Daba, G. Myrothecium as Promising Model for Biotechnological Applications, Potentials and Challenges. J. Sci. Res. 2019, 16, 12126–12131. [Google Scholar] [CrossRef]
- Soares de Melo, I.; Valente, A.; Nessner–Kavamura, V.; Vilela, E.; Nicklin, J. Mycoparasitic nature of Bionectria sp. strain 6.21. J. Plant Prot. Res. 2014, 54. [Google Scholar] [CrossRef]
- Rodriguez, M.; Cabrera, G.; Gozzo, F.; Eberlin, M.; Godeas, A. Clonostachys rosea BAFC3874 as a Sclerotinia sclerotiorum antagonist: Mechanisms involved and potential as a biocontrol agent. J. Appl. Microbiol. 2011, 110, 1177–1186. [Google Scholar] [CrossRef] [PubMed]
- Olson, H.; Benson, D. Induced systemic resistance and the role of binucleate Rhizoctonia and Trichoderma hamatum 382 in biocontrol of Botrytis blight in geranium. Biol. Control 2007, 42, 233–241. [Google Scholar] [CrossRef]
- Erper, İ.; Turkkan, M. Binucleate Rhizoctonia repens Bernard as a Biocontrol Agent against Damping–off Disease of Cucumber Plants. Eur. J. Plant Sci. Biotechnol. 2018, 7, 58–61. [Google Scholar]
- Lima, G.; Ippolito, A.; Nigro, F.; Salerno, M. Effectiveness of Aureobasidium pullulans and Candida oleophila against postharvest strawberry rots. Postharvest Biol. Technol. 1997, 10, 169–178. [Google Scholar] [CrossRef]
- Wachowska, U.; Glowacka, K. Antagonistic interactions between Aureobasidium pullulans and Fusarium culmorum, a fungal pathogen of winter wheat. BioControl 2014, 59, 635–645. [Google Scholar] [CrossRef]
- Bozoudi, D.; Tsaltas, D. The Multiple and Versatile Roles of Aureobasidium pullulans in the Vitivinicultural Sector. Fermentation 2018, 4, 85. [Google Scholar] [CrossRef]
- Zhang, Y.; Liu, S.; Che, Y.; Liu, X. Epicoccins A–D, epipolythiodioxopiperazines from a Cordyceps–colonizing isolate of Epicoccum nigrum. J. Nat. Prod. 2007, 70, 1522–1525. [Google Scholar] [CrossRef] [PubMed]
- Ogórek, R.; Plaskowska, E. Epicoccum nigrum for biocontrol agents in vitro of plant fungal pathogens. Commun. Agric. Appl. Biol. Sci. 2011, 76, 691–697. [Google Scholar] [PubMed]
- Derbalah, A.; Elkot, G. Cultural filtrates of certain microbial isolates as an alternative to powdery mildew chemical control in cucumbers. J. Plant Prot. Res. 2011, 53, 252–260. [Google Scholar] [CrossRef]
- Arya, R. Effect of culture filtrates of Epicoccum purpurascens and Penicillium vermiculatum grown of different nitrogen sources on hatching and mortality of root knot nematode Meloidogyne incognita. In Proceedings of the National Conference on Conquering Impact of Climate Change on Agriculture through Organic Farming–A Global Perspective; Shweta, V.K., Sing, Eds.; B.R.A. University: Hyderabad, India, 20 February 2011; pp. 101–106. [Google Scholar]
- Fávaro, L.; Sebastianes, F.; Araújo, W. Epicoccum nigrum P16, a Sugarcane Endophyte, Produces Antifungal Compounds and Induces Root Growth. PLoS ONE 2012, 7, e36826. [Google Scholar] [CrossRef]
- Guerra–Guimarães, L.; Azinheira, G.; Martins, A.C.; Silva, M.C.; Gichuru, E.K.; Varzea, V.; Bertrand, B. Antagonistic interaction between Epicoccum nigrum and Colletotrichum kahawae, the causal agent of coffee berry disease. In Proceedings of the 21st International Conference on Coffee Science, Montpellier, France, 11 September 2006; ASIC: Allenwinden, Switzerland, 2007; pp. 1284–1290. [Google Scholar]
- Bernal–Vicente, A.; Ros, M.; Pascual, J.A. Increased effectiveness of the Trichoderma harzianum isolate T–78 against Fusarium wilt on melon plants under nursery conditions. J. Sci. Food Agric. 2009, 89, 827–833. [Google Scholar] [CrossRef]
- Marín–Guirao, J.I.; Rodríguez–Romera, P.; Lupión–Rodríguez, B.; Camacho–Ferre, F.; Tello–Marquina, J. Effect of Trichoderma on horticultural seedlings growth promotion depending on inoculum and substrate type. J. Appl. Microbiol. 2016, 121, 1095–1102. [Google Scholar] [CrossRef]
- Kamal, R.; Athisayam, V.; Gusain, S.Y.; Kumar, V. Trichoderma: A Most Common Biofertilizer with Multiple Roles in Agriculture. Biomed. J. Sci. Tech. Res. 2018, 4. [Google Scholar] [CrossRef]

| Pathogens | Plant Host | Abbreviation |
|---|---|---|
| Fusarium oxysporum f. sp. niveum (race 0) | Citrullus lanatus | Fon 0 |
| Fusarium oxysporum f. sp. niveum (race 1) | Citrullus lanatus | Fon 1 |
| Fusarium oxysporum f. sp. niveum (race 2) | Citrullus lanatus | Fon 2 |
| Fusarium oxysporum f. sp. melonis (race 0) | Cucumis melo | Fom 0 |
| Fusarium oxysporum f. sp. melonis (race 1) | Cucumis melo | Fom 1 |
| Fusarium oxysporum f. sp. melonis (race 2) | Cucumis melo | Fom 2 |
| Fusarium oxysporum f. sp. melonis (race 1.2y) | Cucumis melo | Fom 1.2 y |
| Fusarium oxysporum f. sp. melonis (race 1.2w) | Cucumis melo | Fom 1.2 w |
| Monosporascus cannonballus isolate | Citrullus lanatus | Mon |
| Macrophomina phaseolina isolate 1 | Cucumis melo | Mcr1 |
| Macrophomina phaseolina isolate 2 | Cucumis melo | Mcr2 |
| Fusarium solani f. sp. cucurbitae race 1 (=Neocosmospora cucurbitae) | Cucurbita moschata | Fsc R1 |
| Fusarium solani f. sp. cucurbitae race 2 (=Neocosmospora petroliphila) | Cucurbita moschata | Fp |
| Fusarium solani (=Neocosmospora keratoplastica) | Cucumis melo | Fs |
| Antagonists | Source | Abbreviation |
| Epicoccum purpurascens Ehrenb. | Citrullus lanatus | Ep |
| Bionectria ochroleuca Schroers & Samuels (=Clonostachys rosea (Link) Schroers, Samuels, Seifert & W. Gams) | Citrullus lanatus | Bo |
| Myrothecium verrucaria (Alb. & Schwein.) Ditmar | Citrullus lanatus | Mv |
| Aureobasidium pullulans (de Bary) G. Arnaud | Citrullus lanatus | Ap |
| Ceratobasidium sp. (binucleate Rhizoctonia) | Citrullus lanatus | Rb |
| Trichoderma harzianum Rifai | Citrullus lanatus | Th |
| Trichoderma lentiforme (Rehm) P. Chaverri, Samuels & F.B. Rocha | Citrullus lanatus | Tl |
| Trichoderma harzianum | Trichoderma lentiforme | Epicoccum purpurascens | Aureobasidium pullulans | Myrothecium verrucaria | Ceratobasidium sp. | Bionectria ochroleuca | ||||||||||||||||||||||
|---|---|---|---|---|---|---|---|---|---|---|---|---|---|---|---|---|---|---|---|---|---|---|---|---|---|---|---|---|
| Fon 0 | 56.3 | de | ± | 4.5 | 44.3 | fg | ± | 11.3 | 29.6 | abcd | ± | 1.8 | 23.3 | cde | ± | 0.8 | 15.3 | bc | ± | 1.4 | 45.6 | ab | ± | 6.9 | 24.1 | cd | ± | 4.3 |
| Fon 1 | 56.7 | de | ± | 2.1 | 60.6 | cd | ± | 0.8 | 29.0 | bcd | ± | 4.2 | 42.9 | a | ± | 2.2 | 4.0 | cd | ± | 4.5 | 39.9 | bc | ± | 4.6 | 19.8 | d | ± | 1.7 |
| Fon 2 | 39.2 | f | ± | 1.0 | 51.0 | efgh | ± | 1.0 | 4.9 | fg | ± | 6.0 | 7.3 | fg | ± | 5.0 | 3.9 | cd | ± | 4.0 | 21.0 | cd | ± | 5.3 | 7.7 | e | ± | 2.0 |
| Fom 0 | 67.6 | bcd | ± | 1.3 | 65.6 | bcd | ± | 1.5 | 35.9 | ab | ± | 2.7 | 26.7 | bcde | ± | 3.6 | 10.4 | bc | ± | 2.6 | 33.6 | bc | ± | 10.1 | 30.0 | abc | ± | 1.6 |
| Fom 1 | 40.9 | f | ± | 9.8 | 42.4 | h | ± | 6.1 | 16.3 | ef | ± | 0.9 | 20.0 | def | ± | 6.0 | 7.7 | bcd | ± | 4.7 | 37.6 | bc | ± | 9.1 | 32.1 | ab | ± | 2.5 |
| Fom 2 | 47.1 | ef | ± | 2.2 | 49.4 | efgh | ± | 6.6 | 20.2 | de | ± | 3.5 | 40.2 | ab | ± | 6.1 | 27.2 | a | ± | 5.7 | 29.9 | bc | ± | 8.7 | 30.5 | abc | ± | 1.1 |
| Fom 1.2y | 56.2 | de | ± | 1.3 | 47.1 | fgh | ± | 2.5 | 22.3 | cde | ± | 2.2 | 34.6 | abc | ± | 9.6 | 8.6 | bcd | ± | 3.5 | 32.2 | bc | ± | 6.3 | 21.7 | d | ± | 1.4 |
| Fom 1.2w | 60.3 | cd | ± | 0.6 | 59.9 | def | ± | 0.9 | 33.9 | abc | ± | 1.2 | 29.4 | abcd | ± | 2.3 | 14.2 | bc | ± | 3.4 | 36.7 | bc | ± | 14.1 | 32.9 | a | ± | 2.1 |
| Mon | 93.4 | a | ± | 0.7 | 93.3 | a | ± | 0.7 | 10.1 | efg | ± | 11.6 | x 1 | 3.7 | cd | ± | 6.5 | 64.8 | a | ± | 7.6 | x 1 | ||||||
| Mcr1 | 70.2 | bc | ± | 6.3 | 56.1 | defg | ± | 2.4 | x 1 | x 1 | x 1 | 4.3 | d | ± | 7.4 | x 1 | ||||||||||||
| Mcr2 | 72.2 | b | ± | 1.5 | 76.1 | b | ± | 5.1 | 41.3 | a | ± | 2.5 | 19.4 | def | ± | 3.8 | 16.4 | ab | ± | 1.8 | 31.0 | bc | ± | 9.1 | 7.8 | e | ± | 4.7 |
| Fsc R1 | 74.1 | b | ± | 1.2 | 73.4 | bc | ± | 1.6 | 16.6 | ef | ± | 3.5 | 29.3 | abcd | ± | 8.4 | 14.8 | bc | ± | 2.4 | 4.3 | d | ± | 1.3 | 20.1 | d | ± | 4.4 |
| Fp | 70.4 | bc | ± | 1.3 | 65.1 | bcd | ± | 3.6 | 31.1 | abcd | ± | 1.3 | 24.5 | cde | ± | 4.8 | 19.7 | ab | ± | 1.9 | 23.9 | bcd | ± | 4.2 | 25.5 | bcd | ± | 0.5 |
| Fs | 66.1 | bcd | ± | 3.6 | 68.2 | bcd | ± | 1.3 | 30.6 | abcd | ± | 1.7 | 13.8 | fg | ± | 1.9 | 15.0 | bc | ± | 4.7 | 44.9 | ab | ± | 2.6 | 25.3 | bcd | ± | 2.0 |
| Combination Pathogen-Th | Colonization Ability | Combination Pathogen-Tl | Colonization Ability |
|---|---|---|---|
| Fon 0/Th | 1.0 ± 0.0 | Fon 0/Tl | 1.3 ± 0.6 |
| Fon 1/Th | 1.0 ± 0.0 | Fon 1/Tl | 1.0 ± 0.0 |
| Fon 2/Th | 0.7 ± 0.6 | Fon 2/Tl | 1.7 ± 1.6 |
| Fom 0/Th | 1.0 ± 0.0 | Fom 0/Tl | 1.0 ± 0.0 |
| Fom 1/Th | 0.0 ± 0.0 | Fom 1/Tl | 0.0 ± 0.0 |
| Fom 2/Th | 0.0 ± 0.0 | Fom 2/Tl | 0.0 ± 0.0 |
| Fom 1.2 y/Th | 0.7 ± 0.6 | Fom 1.2 y/Tl | 1.0 ± 0.0 |
| Fom 1.2 w/Th | 2.0 ± 0.0 | Fom 1.2 w/Tl | 1.0 ± 0.0 |
| Mon/Th | 4.0 ± 0.0 | Mon/Tl | 4.0 ± 0.0 |
| Mcr1/Th | 3.0 ± 0.0 | Mcr1/Tl | 2.0 ± 0.0 |
| Mcr2/Th | 4.0 ± 0.0 | Mcr2/Tl | 3.0 ± 0.0 |
| Fsc R1/Th | 0.0 ± 0.0 | Fsc R1/Tl | 0.3 ± 0.6 |
| Fp/Th | 2.0 ± 0.0 | Fp/Tl | 1.0 ± 0.0 |
| Fs/Th | 2.0 ± 1.7 | Fs/Tl | 1.0 ± 0.0 |
| Pathogen | Control * | Fermentation Days of Epicoccum purpurascens | ||||||||
|---|---|---|---|---|---|---|---|---|---|---|
| 5 dpi | 10 dpi | 15 dpi | ||||||||
| Extract Doses | Extract Doses | Extract Doses | ||||||||
| 0.5% | 1% | 2% | 0.5% | 1% | 2% | 0.5% | 1% | 2% | ||
| Fon 0 | 41.8 ± 2.3 | 38.3 ± 0.9 | 39.3 ± 1.0 | 39.3 ± 1.3 | 36.7 ± 1.1 | 36.5 ± 0.5 | 38.7 ± 0.8 | 31.0 ± 2.8 | 30.0 ± 2.6 | 29.8 ± 1.5 |
| Fon 1 | 34.0 ± 1.2 | 31.9 ± 0.7 | 27.6 ± 6.3 | 26.7 ± 0.4 | 35.4 ± 1.1 | 31.5 ± 2.6 | 29.4 ± 2.9 | 23.8 ± 4.1 | 20.5 ± 1.3 | 18.0 ± 0.8 |
| Fon 2 | 29.1 ± 2.7 | 32.5 ± 1.7 | 33.4 ± 0.9 | 33.8 ± 0.7 | 28.7 ± 4.9 | 32.5 ± 1.8 | 29.3 ± 1.1 | 19.6 ± 1.5 | 20.0 ± 3.24 | 18.4 ± 2.3 |
| Fom 0 | 38.1 ± 0.9 | 36.9 ± 1.4 | 35.4 ± 1.0 | 30.5 ± 0.6 | 27.1 ± 5.2 | 34.5 ± 1.4 | 25.4 ± 5. 6 | 23.8 ± 2.7 | 25.5 ± 0.9 | 28.5 ± 0.5 |
| Fom 1 | 40.3 ± 0.3 | 41.8 ± 1.6 | 40.6 ± 0.5 | 39.5 ± 2.5 | 39.6 ± 1.2 | 39.1 ± 1.5 | 39.0 ± 1.7 | 37.9 ± 1.2 | 40.2 ± 0.3 | 38.1 ± 0.9 |
| Fom 2 | 30.7 ± 5.0 | 25.5 ± 2.8 | 23.4 ± 2.0 | 23.0 ± 0.7 | 27.7 ± 1.2 | 23.5 ± 1.8 | 23.6 ± 1.7 | 17.4 ± 0.2 | 23.6 ± 4.6 | 28.0 ± 4.1 |
| Fom 1.2y | 41.4 ± 0.4 | 40.5 ± 0.9 | 36.9 ± 0.6 | 36.4 ± 1.6 | 37.5 ± 1.7 | 40.2 ± 0.9 | 39.2 ± 0.8 | 39.0 ± 0.3 | 38.9 ± 1.2 | 35.0 ± 2.8 |
| Fom 1.2w | 39.8 ± 0.8 | 33.0 ± 6.7 | 36.2 ± 2.0 | 38.0 ± 1.0 | 39.0 ± 1.6 | 36.5 ± 4.2 | 36.8 ± 0.7 | 33.8 ± 3.5 | 32.0 ± 2.6 | 25.3 ± 5.4 |
| Mon | 43.4 ± 0.2 | 43.4 ± 0.3 | 43.3 ± 0.0 | 43.3 ± 0.0 | 43.3 ± 0.0 | 43.3 ± 0.0 | 43.3 ± 0.0 | 43.3 ± 0.0 | 43.2 ± 0.0 | 43.2 ± 0.1 |
| Mcr1 | 43.3 ± 0.2 | 42.9 ± 0.6 | 43.5 ± 0.6 | 43.2 ± 0.3 | 43.1 ± 0.3 | 43.2 ± 0.1 | 43.2 ± 0.2 | 43.2 ±0.2 | 42.8 ± 0.4 | 43.1 ± 0.1 |
| Mcr2 | 42.4 ± 1.0 | 36.3 ± 3.3 | 39.5 ± 2.1 | 38.7 ± 2.0 | 42.2 ± 0.7 | 39.8 ± 1.8 | 40.7 ± 0.4 | 34.9 ± 1.0 | 32.2 ± 2.9 | 33.7 ± 1.4 |
| Fsc R1 | 34.1 ± 2.0 | 34.6 ± 0.3 | 33.5 ± 0.3 | 32.1 ± 0.3 | 32.9 ± 0.6 | 32.8 ± 0.1 | 31.8 ± 0.5 | 33.6 ± 0.5 | 32.6 ± 0.1 | 34.1 ± 1.3 |
| Fp | 41.7 ± 1.1 | 38.9 ± 0.6 | 36.2 ± 1.5 | 37.1 ± 0.8 | 40.3 ± 0.3 | 39.7 ± 0.4 | 38.2 ± 0.6 | 33.3 ± 0.3 | 33.2 ± 0.2 | 32.2 ± 0.1 |
| Fs | 43.8 ± 0.0 | 43.3 ± 1.7 | 42.6 ± 1.4 | 42.2 ± 0.1 | 43.3 ± 0.4 | 43.2 ± 0.2 | 43.0 ± 0.2 | 38.9 ± 0.1 | 38.2 ± 0.4 | 38.7 ± 0.2 |
| Source of Variation | Sum of Squares | df | Mean Square | F | p |
|---|---|---|---|---|---|
| Days | 1685.159 | 2 | 842.579 | 195.100 | 0.000 |
| Dose | 74.032 | 2 | 37.016 | 8.571 | 0.000 |
| Pathogen | 10144.267 | 13 | 780.328 | 180.685 | 0.000 |
| Days*Dose | 5.954 | 4 | 1.489 | 0.345 | 0.848 |
| Days*Pathogen | 1604.482 | 26 | 61.711 | 14.289 | 0.000 |
| Dose*Pathogen | 228.520 | 26 | 8.789 | 2.035 | 0.003 |
| Days *Dose*Pathogen | 749.974 | 52 | 14.423 | 3.340 | 0.000 |
| Error | 1153.096 | 267 | 4.319 | 1153.096 | 267 |
| Pathogen | Radial Growth (in mm) of Pathogens Caused by Epicoccum purpurascens | ||||||
|---|---|---|---|---|---|---|---|
| Dual Culture | Liquid Extract | p-Value | |||||
| Fon 0 | 28.0 | ± | 0.7 | 30.3 | ± | 2.1 | 0.1105 |
| Fon 1 | 25.6 | ± | 1.5 | 17.9 | ± | 0.8 | 0.0016 |
| Fon 2 | 19.6 | ± | 1.1 | 19.4 | ± | 2.3 | 0.8456 |
| Fom 0 | 24.6 | ± | 1.0 | 25.9 | ± | 2.5 | 0.3932 |
| Fom 2 | 22.5 | ± | 0.9 | 23.9 | ± | 3.7 | 0.5189 |
| Fom 1.2 y | 30.9 | ± | 0.9 | 38.3 | ± | 2.1 | 0.0001 |
| Fom 1.2 w | 27.0 | ± | 0.5 | 35.7 | ± | 4.1 | 0.0058 |
| Mcr2 | 20.8 | ± | 0.9 | 33.6 | ± | 2.1 | 0.0001 |
| Fsc R1 | 27.1 | ± | 1.1 | 38.2 | ± | 0.6 | 0.0001 |
| Fp | 25.2 | ± | 0.5 | 32.2 | ± | 0.1 | 0.0001 |
| Fs | 28.1 | ± | 0.7 | 38.6 | ± | 0.4 | 0.0001 |
| Black Diamond Watermelon Plants a | |||
| Plants Non-Inoculated | |||
| 1.00 ± 0.00 (0%) | |||
| Plants Inoculated with Antagonists | |||
| Th | Tl | ||
| 1.00 ± 0.00 (0%) | 1.50 ± 0.54 (0%) | ||
| Plants Inoculated with Antagonist + Pathogen and Only Pathogen | |||
| Tl + Pathogen | Th + Pathogen | Pathogen | |
| Fon 0 | 1.50 ± 0.55 (0%) | 1.50 ± 1.22 (17%) | 2.50 ± 0.83 (33%) |
| Fon 1 | 2.66 ± 1.50 (50%) | 3.16 ± 0.98 (67%) | 2.50 ± 0.83 (33%) |
| Fon 2 | 1.50 ± 0.55 (0%) | 1.83 ± 0.98 (33%) | 2.00 ± 0.00 (0%) |
| Mon | 2.17 ± 1.17 (33%) | 1.50 ± 1.22 (17%) | 2.17 ± 0.41 (33%) |
| Mcr1 | 1.00 ± 0.00 (0%) | 2.83 ± 0.98 (50%) | 3.17 ± 1.33 (67%) |
| FscR1 | 1.17 ± 0.41 (0%) | 2.50 ± 1.22 (50%) | 3.00 ± 0.89 (67%) |
| Fp | 1.00 ± 0.00 (0%) | 2.50 ± 1.05 (50%) | 2.17 ± 1.17 (33%) |
| Charentais T Melon Plants a | |||
| Plants Non-Inoculated | |||
| 1.00 ± 0.00 (0%) | |||
| Plants Inoculated with Antagonists | |||
| Th | Tl | ||
| 1.00 ± 0.00 (0%) | 1.00 ± 0.00 (0%) | ||
| Plants Inoculated with Antagonist + Pathogen and Only Pathogen | |||
| Tl + Pathogen | Th + Pathogen | Pathogen | |
| Fom 0 | 1.00 ± 0.00 (0%) | 1.00 ± 0.00 (0%) | 1.50 ± 0.55 (0%) |
| Fom 1 | 3.66 ± 0.82 (100%) | 3.33 ± 0.82 (83%) | 3.50 ± 0.55 (100%) |
| Fom 2 | 2.00 ± 0.00 (0%) | 1.00 ± 0.00 (0%) | 3.33 ± 1.03 (67%) |
| Fom1.2 | 3.50 ± 0.84 (83%) | 3.67 ± 0.82 (83%) | 3.67 ± 0.52 (100%) |
© 2020 by the authors. Licensee MDPI, Basel, Switzerland. This article is an open access article distributed under the terms and conditions of the Creative Commons Attribution (CC BY) license (http://creativecommons.org/licenses/by/4.0/).
Share and Cite
González, V.; Armijos, E.; Garcés-Claver, A. Fungal Endophytes as Biocontrol Agents against the Main Soil-Borne Diseases of Melon and Watermelon in Spain. Agronomy 2020, 10, 820. https://doi.org/10.3390/agronomy10060820
González V, Armijos E, Garcés-Claver A. Fungal Endophytes as Biocontrol Agents against the Main Soil-Borne Diseases of Melon and Watermelon in Spain. Agronomy. 2020; 10(6):820. https://doi.org/10.3390/agronomy10060820
Chicago/Turabian StyleGonzález, Vicente, Eugenia Armijos, and Ana Garcés-Claver. 2020. "Fungal Endophytes as Biocontrol Agents against the Main Soil-Borne Diseases of Melon and Watermelon in Spain" Agronomy 10, no. 6: 820. https://doi.org/10.3390/agronomy10060820
APA StyleGonzález, V., Armijos, E., & Garcés-Claver, A. (2020). Fungal Endophytes as Biocontrol Agents against the Main Soil-Borne Diseases of Melon and Watermelon in Spain. Agronomy, 10(6), 820. https://doi.org/10.3390/agronomy10060820

